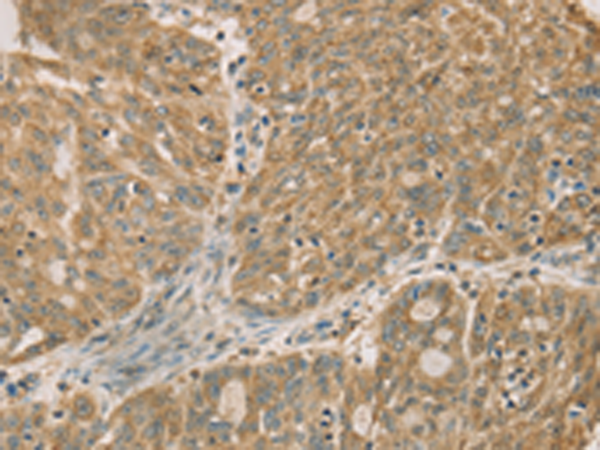

-
分类: 科研抗体货号: P08249别名: REQ; UBID4; ubi-d4应用: WB反应种属: Human, Mouse
-
分类: 科研抗体货号: P08224别名: P62; DYN4应用: IHC反应种属: Human, Mouse, Rat
-
分类: 科研抗体货号: P08240别名: RP11-437A18.1应用: IHC反应种属: Human, Mouse
-
分类: 科研抗体货号: P08247别名: DNL1; DRNI应用: IHC反应种属: Human, Mouse, Rat
-
分类: 科研抗体货号: P08258别名: EB3; RP3; EBF3; EBF3-S应用: WB,IHC反应种属: Human, Mouse, Rat
-
分类: 科研抗体货号: P08239别名: SDR1; RDH17; Rsdr1; DD83.1; SDR16C1; retSDR1应用: WB,IHC反应种属: Human, Mouse
-
分类: 科研抗体货号: P08245别名:应用: IHC反应种属: Human, Mouse, Rat
-
分类: 科研抗体货号: P08256别名: BMD; CMD3B; MRX85; DXS142; DXS164; DXS206; DXS230; DXS239; DXS268; DXS269; DXS270; DXS272应用: IHC反应种属: Human, Mouse
-
分类: 科研抗体货号: P08238别名: SLOS应用: IHC反应种属: Human, Mouse
-
分类: 科研抗体货号: P08244别名: DMRTA3应用: WB,IHC反应种属: Human, Mouse, Rat

鄂公网安备42018502007531号
鄂公网安备42018502007531号

